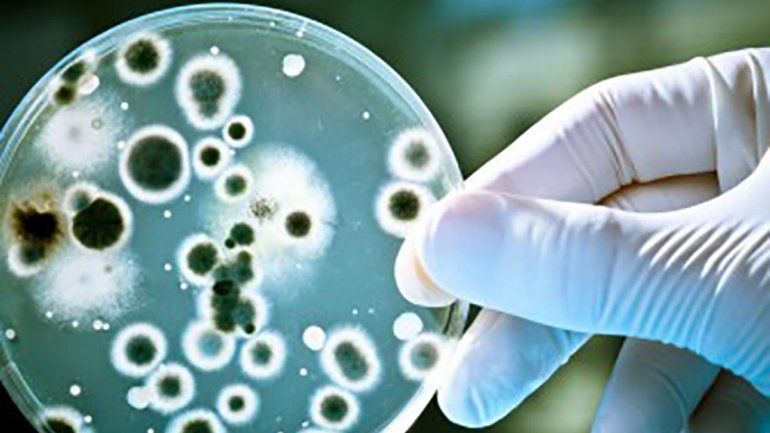
Crecieron las infecciones de transmisión sexual

Sofía Sandoval
Neuquén.- Luego de que se conociera el incremento de casos de enfermedades de transmisión sexual en Junín de los Andes, desde la Dirección de Epidemiología de la provincia informaron que la suba abrupta de casos se dio por un estudio más exhaustivo de los pacientes, que permite registrar los casos que antes se trataban sin figurar en las estadísticas. Sin embargo, alertaron de un incremento en los contagios desde el 2015 y hasta la actualidad.
“No es una situación particular de la provincia de Neuquén, sino de todo el país y también de otras naciones”, sostuvo Cecilia Felizia, referente de Epidemiología de esta dirección. Según detalló Felizia, en los últimos cuatro o cinco años se ve un incremento paulatino de la cantidad de casos de distintas enfermedades de transmisión sexual que incluyen, sobre todo, las secreciones purulentas.
A partir de esta realidad, la Dirección de Epidemiología reforzó sus esfuerzos para llevar adelante una constante vigilancia de todos los casos, que afectan tanto a los adultos como a los bebés recién nacidos de las madres contagiadas.
“La situación particular de Junín de los Andes se dio porque comenzaron una vigilancia intensificada de estos casos a partir del aumento que se nota a nivel global”, detalló la especialista. Agregó que por eso “los mismos casos que antes se trataban sin registro ahora se mandan al laboratorio y pasan a formar parte de la estadística”.
Felizia alertó sobre el incremento de los contagios de distintas enfermedades tanto en la provincia de Neuquén como en el resto del país, y lo atribuyó al relajo de la población.
“En los años 80 y 90, cuando la gente moría de sida, había más conciencia sobre el uso del preservativo. Ahora que esta enfermedad se trata, la gente ya no se cuida con la misma intensidad”, afirmó la especialista.
Publicidad y conductas
Aunque aclaró que el Ministerio de Salud insiste en la publicidad en la prevención para evitar nuevos contagios, la referente de epidemiología, señaló que es imposible controlar de forma exclusiva la conducta que va a tener cada paciente luego de recibir la información.
“Hay una cuestión conductual; hay gente que no le gusta cuidarse y prefiere no hacerlo, por más que esté informada”, apuntó la especialista.
En ese sentido, insistió en la importancia de diferenciar la prevención de enfermedades de transmisión sexual, como la sífilis o la gonorrea, de la anticoncepción. “Cuidarse no es solo prevenir un embarazo no deseado; también hay que incluir un método de barrera para evitar estas enfermedades”, indicó.
La especialista aclaró que el único método de barrera que existe y que previene estos contagios es el preservativo que, además, puede prevenir un embarazo no deseado. El resto de los métodos, por su parte, solo se ocupan de la anticoncepción y no previenen la transmisión de estas infecciones.
13 casos de gonorrea fueron detectados en Junín
Son estadísticas de este año. Mientras que durante todo 2018 solo se habían registrado ocho casos. El aumento responde a una medición más exhaustiva de cada paciente.
También en los recién nacidos
El nivel de incremento en los contagios de enfermedades de transmisión sexual en la provincia llevó a que se detectaran bebés recién nacidos que eran afectados por estas infecciones y eran diagnosticados, por ejemplo, con sífilis congénita.
Cecilia Felizia, referente de la Dirección de Epidemiología de la provincia, detalló que la problemática se puede evitar si se trata a la mujer que está infectada en la gestación con el objetivo de que el bebé nazca sano.
“Para eso, es fundamental que la madre haga todos los controles de embarazo correspondientes, que le permitan llevar adelante un tratamiento adecuado”, sostuvo y agregó que en caso de que no se trate a tiempo, hay que iniciar un tratamiento sobre la enfermedad del bebé.
LEÉ MÁS
Preocupa brote de infecciones de transmisión sexual en Junín de los Andes
Te puede interesar...